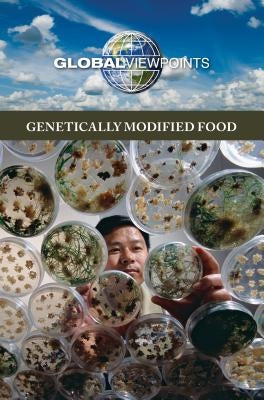
Genetically Modified Food by Merino, No?

Before you leave...
Take 20% off your first order
20% off
Enter the code below at checkout to get 20% off your first order
Discover summer reading lists for all ages & interests!
Find Your Next Read
Thanks for subscribing!
This email has been registered!
Take 20% off your first order
Enter the code below at checkout to get 20% off your first order